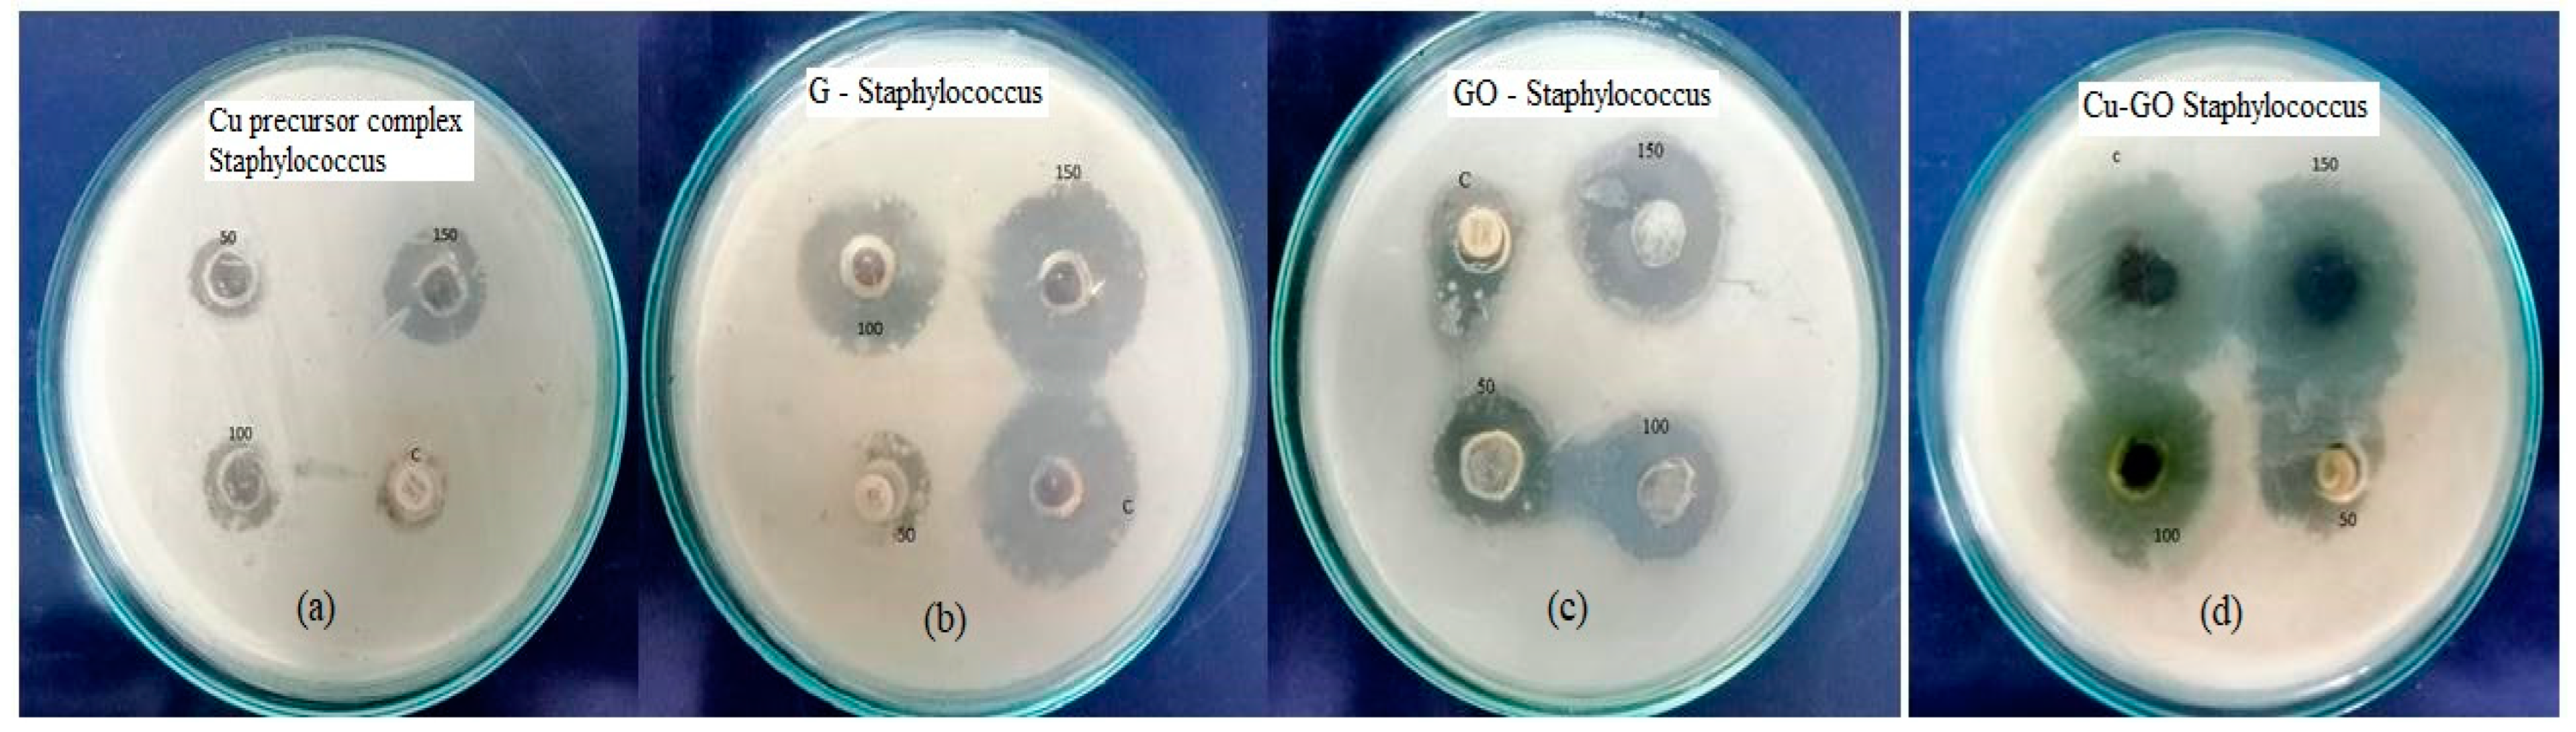
Materials 17 00892 g009

Fine-Tuned Graphene Oxide Nanocomposite: Harnessing Copper(II)–Imidazole Complex for Enhanced Biological Responses and Balanced Photocatalytic Functionality
Abstract
1. Introduction
2. Materials and Methods
2.1. Preparation of [Cu(Im)2Cl2] Complex
2.2. Preparation of Cu-GO
2.3. Adsorption Study of Prepared Samples Using RhB Aqueous Solution
2.4. Photocatalytic Study
2.5. Antimicrobial Study
2.6. Antioxidant Study
2.6.1. DPPH Radical Scavenging Assay
2.6.2. Antioxidant Activity Assay for Cu-GO
2.6.3. DPPH Scavenging Assay Procedure
2.7. Anti-Obesity Study
2.7.1. Dose-Dependent Inhibition of Pancreatic Lipase Activity
2.7.2. Pancreatic Lipase Activity
3. Results
3.1. Characterization of Cu-GO Nanocomposite
3.1.1. X-ray Diffraction (XRD) Analysis
3.1.2. Fourier-Transform Infrared Analysis
3.1.3. Scanning Electron Microscopy (SEM) Imaging
3.1.4. X-ray Photoelectron Spectroscopy (XPS) Analysis
3.1.5. Copper K-Edge X-ray Absorption near Edge Structure (XANES) Spectroscopy
3.2. Optical Properties of Cu-GO Nanocomposite
3.2.1. Diffuse Reflectance Spectra (DRS) Analysis
3.2.2. Photoluminescence Spectra
3.3. Biological Activity Investigations
3.3.1. Antimicrobial Study
3.3.2. Antioxidant Activity DPPH Assay
3.3.3. Anti-Obesity Activity—Pancreatic Lipase Inhibition
3.4. Photocatalytic Activity Investigations
3.4.1. UV–Visible Spectra Analysis
3.4.2. Photodegradation of RhB under Sunlight Irradiation
3.4.3. Comparison of Adsorption Efficiency and Photo-Efficiency
4. Discussion
5. Conclusions
Author Contributions
Funding
Institutional Review Board Statement
Informed Consent Statement
Data Availability Statement
Acknowledgments
Conflicts of Interest
References
- Teixeira-Santos, R.; Belo, S.; Vieira, R.; Mergulhão, F.J.M.; Gomes, L.C. Graphene-Based composites for biomedical applications: Surface modification for enhanced antimicrobial activity and biocompatibility. Biomolecules 2023, 13, 1571. [Google Scholar] [CrossRef]
- Bellier, N.; Baipaywad, P.; Ryu, N.; Lee, J.Y.; Park, H. Recent biomedical advancements in graphene oxide and reduced graphene oxide-based nanocomposite nanocarriers. Biomater. Res. 2022, 26, 65. [Google Scholar] [CrossRef]
- Shahnaz, T.; Hayder, G. Exploring graphene’s antibacterial potential for advanced and sustainable solutions in water treatment. J. Water Process. Eng. 2023, 56, 104530. [Google Scholar] [CrossRef]
- Tiwari, S.K.; Sahoo, S.; Wang, N.; Huczko, A. Graphene research and their outputs: Status and prospect. J. Sci. Adv. Mater. Devices 2020, 5, 10. [Google Scholar] [CrossRef]
- Singh, J.; Jindal, N.; Kumar, V.; Singh, K. Role of green chemistry in synthesis and modification of graphene oxide and its application: A review study. Chem. Phys. Impact 2023, 6, 100185. [Google Scholar] [CrossRef]
- Javadhesari, S.M.; Alipour, S.; Mohammadnejad, S.; Akbarpour, M.R. Antibacterial activity of ultra-small copper oxide(II) nanoparticles synthesized by mechanochemical processing against S. aureus and E. coli. Mater. Sci. Eng. C 2019, 105, 110011. [Google Scholar] [CrossRef] [PubMed]
- Pormohammad, E.; Kargar, P.G.; Bagherzade, G. Loading of green-synthesized Cu nanoparticles on Ag complex containing 1,3,5-triazine Schiff base with enhanced antimicrobial activities. Sci. Rep. 2023, 13, 20421. [Google Scholar] [CrossRef] [PubMed]
- Shown, I.; Hsu, H.-C.; Chang, Y.-C.; Lin, C.-H.; Roy, P.K. Highly efficient visible light photocatalytic reduction of CO2 to hydrocarbon fuels by Cu-nanoparticle decorated graphene oxide. Nano Lett. 2014, 14, 6097. [Google Scholar] [CrossRef]
- Sun, Z.; Fang, W.; Zhao, L.; Wang, H. 3D porous Cu-NPs/g-C3N4 foam with excellent CO2 adsorption and Schottky junction effect for photocatalytic CO2 reduction. Appl. Surf. Sci. 2020, 504, 144347. [Google Scholar] [CrossRef]
- Naser, S.A.E.; Badmus, K.O.; Khotseng, L. Synthesis, properties, and applications of metal organic frameworks supported on graphene oxide. Coatings 2023, 13, 1456. [Google Scholar] [CrossRef]
- Neelgund, G.M.; Oki, A. Folic acid and CuS conjugated graphene oxide: An efficient photocatalyst for explicit degradation of toxic dyes. Appl. Surf. Sci. 2021, 566, 150648. [Google Scholar] [CrossRef]
- Hossain, N.; Islam, M.A.; Chowdhury, M.A.; Alam, A. Advances of nanoparticles employment in dental implant applications. App. Surf. Sci. Adv. 2022, 12, 100341. [Google Scholar] [CrossRef]
- Yang, Z.; Zhou, S.; Feng, X.; Wang, N.; Ola, O.; Zhu, Y. Recent progress in multifunctional graphene-based nanocomposites for photocatalysis and electrocatalysis application. Nanomaterials 2023, 13, 2028. [Google Scholar] [CrossRef]
- Kumar, S.; Himanshi; Prakash, J.; Verma, A.; Suman; Jasrotia, R.; Kandwal, A.; Verma, R.; Godara, S.K.; Khan, M.A.M.; et al. A review on properties and environmental applications of graphene and its derivative-based composites. Catalysts 2023, 13, 111. [Google Scholar] [CrossRef]
- Park, J.; Lee, H.; Lee, K.; Noh, S.; Jin, S.; Jae, J.; Jeong, Y.; Noh, J. ZnO/Graphene oxide on halloysite nanotubes as a superabsorbent nanocomposite photocatalyst for the degradation of organic dyes. Nanomaterials 2023, 13, 1895. [Google Scholar] [CrossRef]
- Yang, K.; Zhang, F.; Chen, Y.; Zhang, H. Recent progress on carbon-based composites in multidimensional applications. Compos. Part A Appl. Sci. Manuf. 2022, 157, 106906. [Google Scholar] [CrossRef]
- Li, J.; Zeng, H.; Zeng, Z.; Zeng, Y.; Xie, T. Promising graphene-based nanomaterials and their biomedical applications and potential risks: A comprehensive review. ACS Biomater. Sci. Eng. 2021, 7, 5363. [Google Scholar] [CrossRef]
- Ban, G.; Hou, Y.; Shen, Z.; Jia, J.; Chai, L.; Ma, C. Potential biomedical limitations of graphene nanomaterials. Int. J. Nanomed. 2023, 18, 1695. [Google Scholar] [CrossRef]
- Mobarak, M.H.; Hossain, N.; Hossain, A.; Mim, J.J.; Khan, F.; Rayhan, M.T.; Islam, M.A.; Chowdhur, M.A. Advances of graphene nanoparticles in dental implant applications—A review. App. Surf. Sci. Adv. 2023, 18, 100470. [Google Scholar] [CrossRef]
- AbouAitah, K.; Sabbagh, F.; Kim, B.S. Graphene oxide nanostructures as nanoplatforms for delivering natural therapeutic agents: Applications in cancer treatment, bacterial infections, and bone regeneration medicine. Nanomaterials 2023, 13, 2666. [Google Scholar] [CrossRef]
- Imani, R.; Mohabatpour, F.; Mostafavi, F. Graphene-based nano-carrier modifications for gene delivery applications. Carbon 2018, 140, 569. [Google Scholar] [CrossRef]
- Ahn, E.; Lee, T.; Gu, M.; Park, M.; Min, S.H.; Kim, B.S. Layer-by-layer assembly for graphene-based multilayer nanocomposites: Synthesis and applications. Chem. Mater. 2015, 27, 3785. [Google Scholar] [CrossRef]
- Yue, M.; Guo, T.; Nie, D.Y.; Zhu, Y.X.; Lin, M. Advances of nanotechnology applied to cancer stem cells. World J. Stem Cells 2023, 15, 514. [Google Scholar] [CrossRef]
- Yang, L.; Shi, P.; Zhao, G.; Xu, J.; Peng, W.; Zhang, J.; Zhang, G.; Wang, X.; Dong, G.; Chen, F. Targeting cancer stem cell pathways for cancer therapy. Signal Transduct. Target. Ther. 2020, 5, 8. [Google Scholar] [CrossRef]
- Ayyakannu Sundaram, G.; Ravikumar, P.; Ramesh, L.; Kesavan, H.; Sadhasivam, S.P.D.; Alagarsamy, S.K.K.; Wang, J. Photocatalytic and antibacterial activities of a Nickel(II)-bipyridine complex modified graphene oxide nanocomposite: Synthesis and characterization. Catalysts 2023, 13, 1200. [Google Scholar] [CrossRef]
- Zankana, M.M.; Al-dalawy, S.M.; Barzinjy, A.A. Synthesis and characterization of bio-nanocomposites: Functionalization of graphene oxide with a biocompatible amino acid. Hybrid Adv. 2023, 3, 100070. [Google Scholar] [CrossRef]
- Alshehri, N.S.; Sharfalddin, A.A.; Domyati, D.; Basaleh, A.S.; Hussien, M.A. Experiment versus theory of copper (II) complexes based imidazole derivatives as anti-cancer agents. J. Indian Chem. Soc. 2022, 99, 100692. [Google Scholar] [CrossRef]
- Zhang, J.; Xu, Y.; Liu, Z.; Yang, W.; Liu, J. A highly conductive porous graphene electrode prepared via in situ reduction of graphene oxide using Cu nanoparticles for the fabrication of high-performance supercapacitors. RSC Adv. 2015, 5, 54275. [Google Scholar] [CrossRef]
- Phetsang, S.; Kidkhunthod, P.; Chanlek, N.; Jakmunee, J.; Mungkornasawaku, P.; Ounnunkad, K. Copper/reduced graphene oxide film modified electrode for non-enzymatic glucose sensing application. Sci. Rep. 2021, 11, 9302. [Google Scholar] [CrossRef] [PubMed]
- Shimizu, K.; Maeshima, H.; Yoshida, H.; Satsuma, A.; Hattori, T. Ligand field effect on the chemical shift in XANES spectra of Cu(II) compounds. Phys. Chem. Chem. Phys. 2001, 3, 862. [Google Scholar] [CrossRef]
- Santhana Krishna Kumar, A.; Tseng, W.B.; Arputharaj, E.; Huang, P.J.; Tseng, W.L.; Bajda, T. Covalent organic framework nanosheets as an enhancer for light-responsive oxidase-like nanozymes: Multifunctional applications in colorimetric sensing, antibiotic degradation, and antibacterial agents. ACS Sustain. Chem. Eng. 2023, 11, 6956–6969. [Google Scholar] [CrossRef]
- Stalin, S.S.; Jino, E.K.K.V. Fabrication of Cu doped ZnO nanocrystals hybridised with Graphene oxide nanosheets as an efficient solar light driven photocatalyst for the degradation of Quinalphos pesticide in aqueous medium. Water Environ. Nanotechnol. 2023, 8, 94–107. [Google Scholar] [CrossRef]
- Thangavel, S.; Krishnamoorthy, K.; Krishnaswamy, V.; Raju, N.; Kim, S.J.; Venugopal, G. Graphdiyne−ZnO nanohybrids as an advanced photocatalytic material. J. Phys. Chem. C 2015, 119, 22057–22065. [Google Scholar] [CrossRef]
- Weng, B.; Yang, M.Q.; Zhang, N.; Xu, Y.J. Toward the enhanced photo-activity and photo-stability of ZnO nanospheres via intimate surface coating with reduced graphene oxide. J. Mater. Chem. A 2014, 2, 9380–9389. [Google Scholar] [CrossRef]
- Li, X.; Wang, Q.; Zhao, Y.; Wu, W.; Chen, J.; Meng, H. Green synthesis and photo-catalytic performances for ZnO-reduced graphene oxide nanocomposites. J. Colloid Interface Sci. 2013, 411, 69–75. [Google Scholar] [CrossRef] [PubMed]
- Rajendrachari, S.; Taslimi, P.; Karaoglanli, A.C.; Uzun, O.; Alp, E.; Jayaprakash, G.K. Photocatalytic degradation of Rhodamine B (RhB) dye in wastewater and enzymatic inhibition study using cauliflower shaped ZnO nanoparticles synthesized by a novel one-pot green synthesis method. Arab. J. Chem. 2021, 14, 103180. [Google Scholar] [CrossRef]
- Maruthupandy, M.; Qin, P.; Muneeswaran, T.; Gandhi, G.R.; Quero, F.; Song, J.M. Graphene-Zinc oxide Nanocomposites (G-ZnO NCs): Synthesis, characterization and their photocatalytic degradation of dye molecules. Mater. Sci. Eng. B 2020, 254, 114516. [Google Scholar] [CrossRef]
- Zhang, C.; Zhang, J.; Su, Y.J.; Xu, M.; Yang, Z.; Zhang, Y.F. ZnO Nanowire/reduced graphene oxide nanocomposites for significantly enhanced photo-catalytic degradation of Rhodamine-6G. Phys. E Low-Dimens. Syst. Nanostruct. 2014, 56, 251–255. [Google Scholar] [CrossRef]
- Wang, F.; Zhou, Y.; Pan, X.; Lu, B.; Huang, J.; Ye, Z. Enhanced photocatalytic properties of ZnO nanorods by electrostatic self-assembly with reduced graphene oxide. Phys. Chem. Chem. Phys. 2018, 20, 6959. [Google Scholar] [CrossRef]
- Shekofteh-Gohari, M.; Habibi-Yangjeh, A. Novel magnetically separable ZnO/AgBr/Fe3O4/Ag3VO4 nanocomposites with tandem n–n heterojunctions as highly efficient visible light driven photocatalysts. RSC Adv. 2016, 6, 2402–2413. [Google Scholar] [CrossRef]
- Zhao, C.; Shao, C.; Li, X.; Tao, R.; Zhou, X.; Liu, Y. Magnetically separable Bi2MoO6/ZnFe2O4 heterostructure nanofibers: Controllable synthesis and enhanced visible light photocatalytic activity. J. Alloys Compd. 2018, 747, 916–925. [Google Scholar] [CrossRef]
- Pusty, M.; Rana, A.K.; Kumar, Y.; Sathe, V.; Sen, S.; Shirage, P. Synthesis of partially reduced graphene oxide/silver nanocomposite and its inhibitive action on pathogenic fungi grown under ambient conditions. ChemistrySelect 2016, 1, 4235. [Google Scholar] [CrossRef]
- Li, Y.; Gao, W.; Ci, L.; Wang, C.; Ajayan, P.M. Catalytic performance of Pt nanoparticles on reduced graphene oxide for methanol electro-oxidation. Carbon 2010, 48, 1124. [Google Scholar] [CrossRef]
- Allen, M.J.; Tung, V.C.; Kaner, R.B. Honeycomb carbon: A review of graphene. Chem. Rev. 2010, 110, 132. [Google Scholar] [CrossRef]
- Parimelazhagan, V.; Chinta, A.; Shetty, G.G.; Maddasani, S.; Tseng, W.; Ethiraj, J.; Sundaram, G.A.; Kumar, A.S.K. Process optimization and equilibrium, thermodynamic, and kinetic modeling of toxic Congo red dye adsorption from aqueous solutions using a copper ferrite nanocomposite adsorbent. Molecules 2024, 29, 418. [Google Scholar] [CrossRef]
- Leon, A.; Reuquen, P.; Garin, C.; Segura, R.; Vargas, P.; Zapata, P.; Orihuela, P.A. FTIR and Raman characterization of TiO2 nanoparticles coated with polyethylene glycol as carrier for 2-methoxyestradiol. Appl. Sci. 2017, 7, 49. [Google Scholar] [CrossRef]
- Glass, D.; Quesada-Cabrera, R.; Bardey, S.; Promdet, P.; Sapienza, R.; Keller, V.; Maier, S.A.; Caps, V.; Parkin, I.P.; Cortes, E. Probing the role of atomic defects in photocatalytic systems through photoinduced enhanced Raman scattering. ACS Energy Lett. 2021, 6, 4273. [Google Scholar] [CrossRef]
- Liu, Y.P.; Lv, Y.T.; Guan, J.F.; Khoso, F.M.; Jiang, X.Y.; Chen, J.; Li, W.J.; Yu, J.G. Rational design of three-dimensional graphene/graphene oxide-based architectures for the efficient adsorption of contaminants from aqueous solutions. J. Mol. Liq. 2021, 343, 117709. [Google Scholar] [CrossRef]
- Metryka, O.; Wasilkowski, D.; Adamczyk-Habrajska, M.; Mrozik, A. Undesirable consequences of the metallic nanoparticles action on the properties and functioning of Escherichia coli, Bacillus cereus and Staphylococcus epidermidis membranes. J. Hazard. Mater. 2023, 446, 130728. [Google Scholar] [CrossRef]
- Gao, S.; Huang, M.; Sun, Z.; Li, D.; Xie, C.; Feng, L.; Liu, S.; Zheng, K.; Pang, Q. A new mixed-ligand lanthanum(III) complex with salicylic acid and 1,10-phenanthroline: Synthesis, characterization, antibacterial activity, and underlying mechanism. J. Mol. Struct. 2021, 1225, 129096. [Google Scholar] [CrossRef]
- Sundaram, G.A.; Murugesan, D.; Kanniah, R.; Muniyandi, G.; Ramesh, L.; Alagarsamy, S.K.K. Synthesis, characterization, antibacterial and photocatalytic studies of metal oxides coupled nanocomposites. ChemistrySelect 2024. accepted. [Google Scholar]

| Sample ID | K | λ (Ȧ) | β | θ | D (nm) |
|---|---|---|---|---|---|
| G | 0.94 | 1.5406 | 0.25019 | 13.2150 | 59.47 |
| GO | 0.94 | 1.5406 | 0.75321 | 6.4361 | 19.34 |
| Cu-GO | 0.94 | 1.5406 | 0.86792 | 4.9691 | 16.75 |
| Sample ID | Zone of Inhibition (mm/mL) | |||
|---|---|---|---|---|
| 50 µL | 100 µL | 150 µL | Control | |
| Cu precursor complex | 08 | 09 | 10 | 15 |
| G | 9 | 11 | 12 | 12 |
| GO | 10 | 12 | 14 | 15 |
| Cu-GO | 13 | 14 | 15 | 18 |
| Test | Concentration of the Sample (mg/mL) | % of Inhibition Cu-GO | Ascorbic Acid |
|---|---|---|---|
| DPPH assay | 50 | 12.7 | 15.2 |
| 100 | 21.9 | 25.6 | |
| 150 | 32.7 | 35.8 | |
| 200 | 40.8 | 45.3 | |
| IC50 value | - | 246.05 | 222.13 |
| Test | Concentration of the Sample (mg/mL) | % of Inhibition Cu-GO | Orlistat |
|---|---|---|---|
| Pancreatic Lipase enzyme activity | 50 | 15 | 20 |
| 100 | 25 | 30 | |
| 150 | 35 | 40 | |
| 200 | 45 | 50 | |
| IC50 value | - | 225 | 200 |
| Catalytic Name | Rate Constant K(min−1)/% Reduction | Reference |
|---|---|---|
| Graphdiyne–Zinc Oxide (GD-ZnO) | 0.00298 | [33] |
| Nano-hybrid | 0.02263 | [34] |
| ZnO–10% reduced graphene oxide | NA | [35] |
| ZnO-reduced graphene oxide nanocomposites | NA | [36] |
| ZnO nanoparticle | NA | [37] |
| Graphene–zinc oxide nanocomposites | NA | [38] |
| ZnO NW/RGO nanocomposites | NA | [39] |
| ZnO nanorods | 0.029 | [40] |
| ZnO/AgBr/Fe3O4/Ag3VO4 | 0.0034 | [41] |
| Graphene oxide | 35.1% | This study |
| Cu-GO nano-composite | 73.8% | This study |
Disclaimer/Publisher’s Note: The statements, opinions and data contained in all publications are solely those of the individual author(s) and contributor(s) and not of MDPI and/or the editor(s). MDPI and/or the editor(s) disclaim responsibility for any injury to people or property resulting from any ideas, methods, instructions or products referred to in the content. |
© 2024 by the authors. Licensee MDPI, Basel, Switzerland. This article is an open access article distributed under the terms and conditions of the Creative Commons Attribution (CC BY) license (https://creativecommons.org/licenses/by/4.0/).
Share and Cite
Sundaram, G.A.; Kumaravelu, S.; Tseng, W.-L.; Pham, P.V.; Kumar, A.S.K.; Parimelazhagan, V. Fine-Tuned Graphene Oxide Nanocomposite: Harnessing Copper(II)–Imidazole Complex for Enhanced Biological Responses and Balanced Photocatalytic Functionality. Materials 2024, 17, 892. https://doi.org/10.3390/ma17040892
Sundaram GA, Kumaravelu S, Tseng W-L, Pham PV, Kumar ASK, Parimelazhagan V. Fine-Tuned Graphene Oxide Nanocomposite: Harnessing Copper(II)–Imidazole Complex for Enhanced Biological Responses and Balanced Photocatalytic Functionality. Materials. 2024; 17(4):892. https://doi.org/10.3390/ma17040892
Chicago/Turabian StyleSundaram, Ganeshraja Ayyakannu, Sowndarya Kumaravelu, Wei-Lung Tseng, Phuong V. Pham, Alagarsamy Santhana Krishna Kumar, and Vairavel Parimelazhagan. 2024. "Fine-Tuned Graphene Oxide Nanocomposite: Harnessing Copper(II)–Imidazole Complex for Enhanced Biological Responses and Balanced Photocatalytic Functionality" Materials 17, no. 4: 892. https://doi.org/10.3390/ma17040892
APA StyleSundaram, G. A., Kumaravelu, S., Tseng, W.-L., Pham, P. V., Kumar, A. S. K., & Parimelazhagan, V. (2024). Fine-Tuned Graphene Oxide Nanocomposite: Harnessing Copper(II)–Imidazole Complex for Enhanced Biological Responses and Balanced Photocatalytic Functionality. Materials, 17(4), 892. https://doi.org/10.3390/ma17040892

